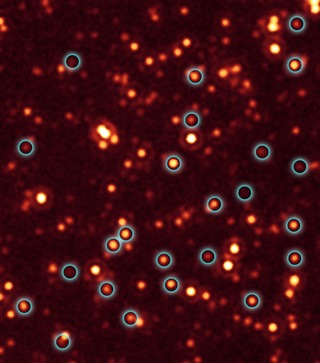

Credit: NASA/JPL-Caltech/E. Daddi (CEA France)
Observation • October 25th, 2008 • ssc2007-17a2
ssc2007-17a2
Astronomers have unmasked hundreds of black holes hiding deep inside dusty galaxies billions of light-years away.
The massive, growing black holes, discovered by NASA's Spitzer and Chandra space telescopes, represent a large fraction of a long-sought missing population. Their discovery implies there were hundreds of millions of additional black holes growing in our young universe, more than doubling the total amount known at that distance.
"Active, supermassive black holes were everywhere in the early universe," said Mark Dickinson of the National Optical Astronomy Observatory in Tucson, Ariz. "We had seen the tip of the iceberg before in our search for these objects. Now, we can see the iceberg itself." Dickinson is a co-author of two new papers appearing in the Nov. 10 issue of the Astrophysical Journal. Emanuele Daddi of the Commissariat a l'Energie Atomique in France led the research.
The findings are also the first direct evidence that most, if not all, massive galaxies in the distant universe spent their youths building monstrous black holes at their cores.
For decades, a large population of active black holes has been considered missing. These highly energetic structures belong to a class of black holes called quasars. A quasar consists of a doughnut-shaped cloud of gas and dust that surrounds and feeds a budding supermassive black hole. As the gas and dust are devoured by the black hole, they heat up and shoot out X-rays. Those X-rays can be detected as a general glow in space, but often the quasars themselves can't be seen directly because dust and gas blocks them from our view.
"We knew from other studies from about 30 years ago that there must be more quasars in the universe, but we didn't know where to find them until now," said Daddi.
About the Object
- Name
- GOODS South Field
- Type
- Cosmology > Morphology > Deep Field
- Star > Evolutionary Stage > Black Hole
- Distance
- 9,000,000,000 Light Years
- Redshift
- 3
Color Mapping
| Band | Wavelength | Telescope |
| Infrared | 24.0 µm | Spitzer MIPS |